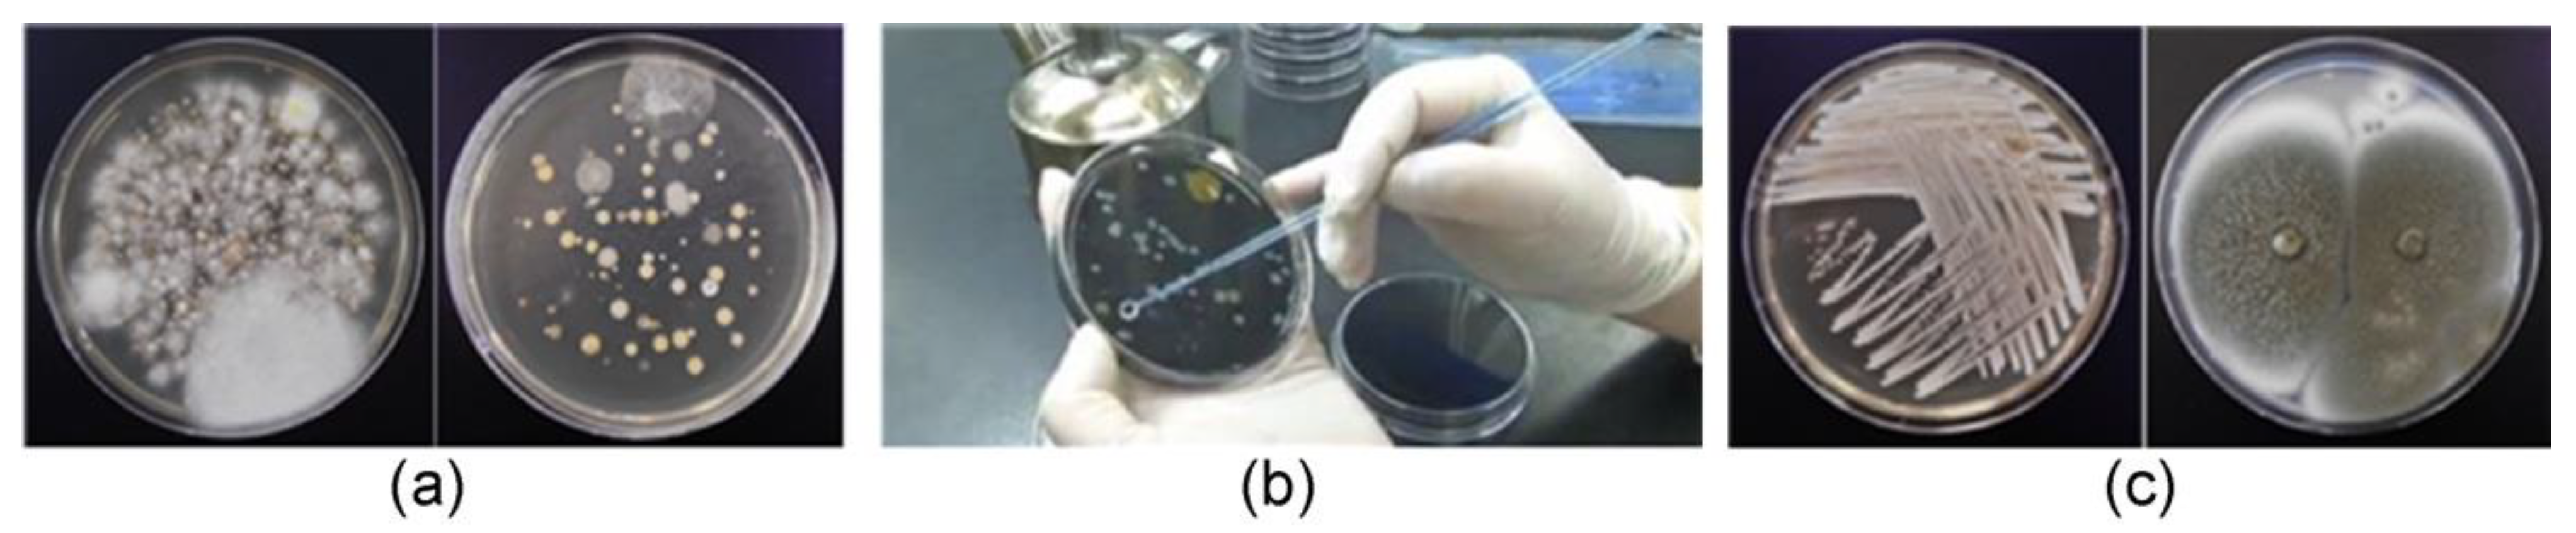
Ijerph 19 06667 g001
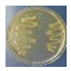
Ijerph 19 06667 i002
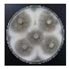
Ijerph 19 06667 i007
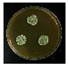
Ijerph 19 06667 i008

Survey of Airborne Microorganisms in an Arcade-Type Traditional Market in Anseong, South Korea
Abstract
1. Introduction
2. Materials and Methods
2.1. Study Site
2.2. Air Sampling and Microbial Culture
2.3. Microbiological Identification and Analysis
2.3.1. Pure Culture Isolation
2.3.2. Molecular Analysis
3. Results
3.1. Concentration and Type of Airborne Microorganisms
3.1.1. Concentrations of Airborne Microorganisms
3.1.2. Identification of Airborne Microorganisms
4. Discussion
5. Conclusions
Author Contributions
Funding
Institutional Review Board Statement
Informed Consent Statement
Data Availability Statement
Conflicts of Interest
References
- Ryu, T.C. Analysis of tourist attractiveness of traditional market using IPA. J. Hosp. Tour. Res. 2011, 26, 133–147. [Google Scholar]
- Lee, M.W. A study on the ways of activating the Korean conventional markets. J. Ind. Econ. Bus. 2005, 18, 701–718. [Google Scholar]
- Sung, J.Y.; Jeon, S.G. Case study of Suyu Mart’s revitalization strategy, Korea. Bus. Rev. 2009, 12, 51–82. [Google Scholar]
- Kim, H.Y.; Yang, D.W. A study about design management for invigorating traditional market: Focusing on the cultural tourism market development project. J. Basic Des. Art 2017, 18, 165–176. [Google Scholar]
- Madigan, M.T.; Martinko, J.M. BrockBiology of Microbiology, 11th ed.; Pearson Prentice Hall: Upper Saddle River, NJ, USA, 2006. [Google Scholar]
- Go, G.P. Bio-aerosol exposure and human health risk assessment. Air Clean. Technol. 2007, 76, 50–56. [Google Scholar]
- Koh, J.-Y.; Jang, C.-G.; Cha, M.-J.; Park, K.-N.; Kim, M.-K.; Kim, J.-S. Distribution and characteristics of microorganisms associated with settled particles during Asian dust events. Korean J. Microbiol. 2012, 48, 134–140. [Google Scholar] [CrossRef][Green Version]
- Lim, Y.T.; Jeon, S.M. A study on typology of traditional markets and its vitalization. J. Reg. Stud. Dev. 2010, 10, 165–190. [Google Scholar]
- Kim, N.Y.; Kim, Y.R.; Kim, M.G.; Cho, D.W.; Kim, J.S. Isolation and characterization of airborne bacteria and fungi in indoor environment of elementary schools. Korean J. Microbiol. 2007, 43, 193–200. [Google Scholar]
- Osman, M.E.; Ibrahim, H.Y.; Yousef, F.A.; Elnasr, A.A.; Saeed, Y.; Hameed, A.A. A study on microbiological contamination on air quality in hospitals in Egypt. Indoor Built. Environ. 2018, 27, 953–968. [Google Scholar] [CrossRef]
- Ngan, W.Y.; Rao, S.; Chan, L.C.; Sekoai, P.T.; Pu, Y.; Yao, Y.; Fung, A.H.Y.; Habimana, O.; Habimana, O. Impacts of wet market modernization levels and hygiene practices on the microbiome and microbial safety of wooden cutting boards in Hong Kong. Microorganisms 2020, 8, 1941. [Google Scholar] [CrossRef] [PubMed]
- Guo, K.; Qian, H.; Zhao, D.; Ye, J.; Zhang, Y.; Kan, H.; Zhao, Z.; Deng, F.; Huang, C.; Zhao, B.; et al. Indoor exposure levels of bacteria and fungi in residences, schools, and offices in China: A systematic review. Indoor Air 2020, 30, 1147–1165. [Google Scholar] [CrossRef] [PubMed]
- National Institute of Environmental Research. Standards for Indoor Air Quality Testing, 2020–2023, ES 02701, 1c; Living Environment Research Division: Incheon, Korea, 2020. [Google Scholar]
- Son, B.H.; Kang, K.H.; Lee, J.S. A study on the measurement of total airborne bacteria in the process of dismantling the non-structure of old building. In Proceedings of the Korean Institute of Building Construction Conference, Jeju, Korea, 21 May 2021; pp. 313–314. [Google Scholar]
- 70% of Homes Exceed Total Airborne Bacteria Standard. 2011. Available online: www.me.go.kr/home/web/board/read.do?menuId=286&boardId=178041&boardMasterId=1 (accessed on 18 October 2021).
- Park, K.S.; Choi, S.G.; Hong, J.K. A study on the distribution of indoor concentration of microorganism in commercial building. Facil. Eng. Pap. 2006, 18, 620–626. [Google Scholar]
- Kobayashi, K.; Ehrlich, S.D.; Albertini, A.; Amati, G.; Andersen, K.K.; Arnaud, M.; Asai, K.; Ashikaga, S.; Aymerich, S.; Bessieres, P.; et al. Essential Bacillus subtilis genes. Proc. Natl. Acad. Sci. USA 2003, 100, 4678–4683. [Google Scholar] [CrossRef] [PubMed]
- Nieminen, T.; Rintaluoma, N.; Andersson, M.; Taimisto, A.M.; Ali-Vehmas, T.; Seppälä, A.; Priha, O.; Salkinoja-Salonen, M.; Salkinoja-Salonen, M. Toxinogenic Bacillus pumilus and Bacillus licheniformis from mastitic milk. Vet. Microbiol. 2007, 124, 329–339. [Google Scholar] [CrossRef] [PubMed]
- Vary, P.S.; Biedendieck, R.; Fuerch, T.; Meinhardt, F.; Rohde, M.; Deckwer, W.D.; Jahn, D. Bacillus megaterium—From simple soil bacterium to industrial protein production host. Appl. Microbiol. Biotechnol. 2007, 76, 957–967. [Google Scholar] [CrossRef] [PubMed]
- Aquilanti, L.; Garofalo, C.; Osimani, A.; Clementi, F. Ecology of lactic acid bacteria and coagulase negative cocci in fermented dry sausages manufactured in Italy and other Mediterranean countries: An Overview. Int. Food Res. J. 2016, 23, 429–445. [Google Scholar]
- Samson, R.A.; Houbraken, J.; Summerbell, R.C.; Flannigan, B.; Miller, J.D. Common and important species of fungi and actinomycetes in indoor environments. In Microorganisms in Home and Indoor Work Environments; CRC: London, UK, 2001; pp. 287–292. [Google Scholar]
- Leslie, J.F.; Bandyopadhyay, R.; Visconti, A. (Eds.) Mycotoxins: Detection Methods, Management, Public Health, and Agricultural Trade; CABI Publishing: Wallingford, UK, 2008; ISBN 978-1845930820. [Google Scholar]
- Adan, O.C.G. Fundamentals of Mold Growth in Indoor Environments and Strategies for Healthy Living; Springer Science and Business Media: Berlin, Germany, 2011; ISBN 9086867227. [Google Scholar]
- Iwen, P.C.; Sigler, L.; Noel, R.K.; Freifeld, A.G. Mucor circinelloides was identified by molecular methods as a cause of primary cutaneous zygomycosis. J. Clin. Microbiol. 2007, 45, 636–640. [Google Scholar] [CrossRef] [PubMed]
- Douwes, J.; Thorne, P.; Pearce, N.; Heederik, D. Bioaerosol health effects and exposure assessment: Progress and prospects. Ann. Occup. Hyg. 2003, 47, 187–200. [Google Scholar]

| Medium | Component | Amount |
|---|---|---|
| NA | Bacto peptone | 5.00 g |
| Beef extract | 3.00 g | |
| Agar | 15.00 g | |
| Distilled water | 1000 mL | |
| SDAC | Enzymatic digest of casein | 5.00 g |
| Enzymatic digest of animal tissue | 5.00 g | |
| Dextrose | 40.00 g | |
| Agar | 15.00 g | |
| Chloramphenicol | 0.05 g | |
| Distilled water | 1000 mL |
| Location | Category | January | April | July | October | ||||
|---|---|---|---|---|---|---|---|---|---|
| 1st (01/15) | 2nd (01/30) | 1st (04/14) | 2nd (04/29) | 1st (07/15) | 2nd (07/30) | 1st (10/15) | 2nd (10/30) | ||
| Entrance | Temperature (°C) | −2.1 | −1.7 | 13.4 | 16.2 | 24.3 | 26.1 | 19.4 | 17.1 |
| Relative humidity (%) | 63.0 | 55.7 | 48.9 | 50.0 | 72.1 | 80.4 | 64.8 | 60.9 | |
| Bacterial concentration (CFU/m3) | 8.1 × 102 | 7.9 × 102 | 6.5 × 102 | 6.3 × 102 | 8.0 × 102 | 8.4 × 102 | 9.3 × 102 | TNTC | |
| Mean bacterial concentration [CFU/m3] (SD) | 8.0 × 102 (14.1) | 6.4 × 102 (14.1) | 8.2 × 102 (28.3) | - | |||||
| Fungal concentration (CFU/m3) | 5.2 × 102 | 5.6 × 102 | 4.5 × 102 | 4.6 × 102 | 6.6 × 102 | 6.7 × 102 | 6.9 × 102 | 7.0 × 102 | |
| Mean fungal concentration [CFU/m3] (SD) | 5.4 × 102 (28.3) | 4.55 × 102 (7.1) | 6.65 × 102 (14.1) | 6.95 × 102 (7.1) | |||||
| Intersection | Temperature (°C) | −1.0 | 0.9 | 14.4 | 17.3 | 25.1 | 27.0 | 20.3 | 18.3 |
| Relative humidity (%) | 62.1 | 56.0 | 49.0 | 51.1 | 72.9 | 80.8 | 64.0 | 60.9 | |
| Bacterial concentration (CFU/m3) | 8.8 × 102 | 8.5 × 102 | 7.7 × 102 | 6.9 × 102 | 9.0 × 102 | 9.1 × 102 | TNTC | TNTC | |
| Mean bacterial concentration [CFU/m3] (SD) | 8.65 × 102 (21.2) | 7.3 × 102 (56.6) | 9.05 × 102 (7.1) | - | |||||
| Fungal concentration (CFU/m3) | 6.0 × 102 | 5.8 × 102 | 4.9 × 102 | 4.9 × 102 | 7.0 × 102 | 7.4 × 102 | 8.7 × 102 | 8.4 × 102 | |
| Mean fungal concentration [CFU/m3] (SD) | 5.9 × 102 (14.1) | 4.9 × 102 (0.0) | 7.2 × 102 (28.3) | 8.55 × 102 (21.2) | |||||
| No. | Bacterial Species | Detection Frequency |
|---|---|---|
| 1 | Bacillus subtilis | 16/16 (100%) |
| 2 | Bacillus licheniformis | 16/16 (100%) |
| 3 | Bacillus megaterium | 16/16 (100%) |
| 4 | Staphylococcus xylosus | 16/16 (100%) |
| 5 | Brevibacterium frigoritolerans | 5/16 (31%) |
| 6 | Bacillus vallismortis | 5/16 (31%) |
| 7 | Pantoea agglomerans | 5/16 (31%) |
| 8 | Kocuria rosea | 3/16 (19%) |
| 9 | Bacillus altitudinis | 2/16 (13%) |
| 10 | Bacillus thuringiensis | 2/16 (13%) |
| 11 | Exiguobacterium acetylicum | 2/16 (13%) |
| 12 | Arthrobacter aurescens | 2/16 (13%) |
| 13 | Bacillus velezensis | 2/16 (13%) |
| 14 | Deinococcus soli | 2/16 (13%) |
| 15 | Arthrobacter luteolus | 2/16 (13%) |
| 16 | Psychrobacter faecalis | 2/16 (13%) |
| 17 | Staphylococcus equorum | 2/16 (13%) |
| 18 | Exiguobacterium indicum | 1/16 (6%) |
| 19 | Acinetobacter schindleri | 1/16 (6%) |
| 20 | Bacillus zhangzhouensis | 1/16 (6%) |
| 21 | Bacillus cereus | 1/16 (6%) |
| 22 | Bacillus flexus | 1/16 (6%) |
| 23 | Bacillus muralis | 1/16 (6%) |
| 24 | Bacillus wiedmannii | 1/16 (6%) |
| 25 | Exiguobacterium sibiricum | 1/16 (6%) |
| 26 | Kocuria rhizophila | 1/16 (6%) |
| No. | Fungal Species | Detection Frequency |
|---|---|---|
| 1 | Aspergillus niger | 16/16 (100%) |
| 2 | Fusarium sporotrichioides | 16/16 (100%) |
| 3 | Penicillium variabile | 8/16 (50%) |
| 4 | Rhizomucor pusillus | 8/16 (50%) |
| 5 | Rhizopus microsporus | 4/16 (25%) |
| 6 | Aspergillus fumigatus | 3/16 (19%) |
| 7 | Penicillium citrinum | 3/16 (19%) |
| 8 | Phoma sp. | 3/16 (19%) |
| 9 | Alternaria alternata | 3/16 (19%) |
| 10 | Penicillium sp. | 3/16 (19%) |
| 11 | Fungal endophyte | 2/16 (13%) |
| 12 | Irpex lacteus | 2/16 (13%) |
| 13 | Aspergillus luchuensis | 2/16 (13%) |
| 14 | Aspergillus oryzae | 2/16 (13%) |
| 15 | Curvularia lycopersici | 1/16 (6%) |
| 16 | Emericella dentata | 1/16 (6%) |
| 17 | Aspergillus sp. | 1/16 (6%) |
| 18 | Emericella sp. | 1/16 (6%) |
| 19 | Penicillium janthinellum | 1/16 (6%) |
| 20 | Trichoderma longibrachiatum | 1/16 (6%) |
| 21 | Trichoderma sp. | 1/16 (6%) |
| Category | Pathogenicity | Microorganism | Pure Culture Isolation | Characteristics |
|---|---|---|---|---|
| Bacteria | Pathogenic | Bacillus subtilis | ![]() | Partially pathogenic Causes eye and urinary tract infections |
| Bacillus licheniformis | ![]() | Pathogenic Causes an infection in immunocompromised patients | ||
| Staphylococcus xylosus | ![]() | Partly pathogenic Causes urinary tract infection in females and skin lesions | ||
| Non-pathogenic | Bacillus megaterium | ![]() | Inhibits the growth of pathogenic microorganisms | |
| Fungi | Pathogenic | Aspergillus niger | ![]() | Pathogenic Causes infection in the ear canal |
| Fusarium sporotrichioides | ![]() | Pathogenic Fungal toxins have negative effects in humans | ||
| Rhizomucor pusillus | ![]() | Pathogenic Causes lung disease | ||
| Non-pathogenic | Penicillium variabile | ![]() | Exists in the indoor environment |
Publisher’s Note: MDPI stays neutral with regard to jurisdictional claims in published maps and institutional affiliations. |
© 2022 by the authors. Licensee MDPI, Basel, Switzerland. This article is an open access article distributed under the terms and conditions of the Creative Commons Attribution (CC BY) license (https://creativecommons.org/licenses/by/4.0/).
Share and Cite
Song, C.-G.; Park, J.-H.; Lee, P.-M.; Jung, M.-G. Survey of Airborne Microorganisms in an Arcade-Type Traditional Market in Anseong, South Korea. Int. J. Environ. Res. Public Health 2022, 19, 6667. https://doi.org/10.3390/ijerph19116667
Song C-G, Park J-H, Lee P-M, Jung M-G. Survey of Airborne Microorganisms in an Arcade-Type Traditional Market in Anseong, South Korea. International Journal of Environmental Research and Public Health. 2022; 19(11):6667. https://doi.org/10.3390/ijerph19116667
Chicago/Turabian StyleSong, Chan-Geun, Jang-Hyun Park, Pum-Mook Lee, and Myeong-Gyu Jung. 2022. "Survey of Airborne Microorganisms in an Arcade-Type Traditional Market in Anseong, South Korea" International Journal of Environmental Research and Public Health 19, no. 11: 6667. https://doi.org/10.3390/ijerph19116667
APA StyleSong, C.-G., Park, J.-H., Lee, P.-M., & Jung, M.-G. (2022). Survey of Airborne Microorganisms in an Arcade-Type Traditional Market in Anseong, South Korea. International Journal of Environmental Research and Public Health, 19(11), 6667. https://doi.org/10.3390/ijerph19116667